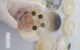

De dez amostras, apenas duas apresentavam contagem dentro dos limites aceitáveis para consumo humano
Um estudo da Universidade Federal da Paraíba (UFPB) revelou que a goma de mandioca vendida em alguns supermercados de João Pessoa contém a presença de bactérias e fungos, podendo ocasionar infecções alimentares ao consumidor. A pesquisa analisou dez estabelecimentos, divididos entre o Centro da capital e os bairros de Castelo Branco, Bancários, Jardim São Paulo e Mangabeira.
O trabalho científico foi realizado no Laboratório de Endemias do Núcleo de Medicina Tropical (Numetrop), do Centro de Ciências da Saúde (CCS), pelos professores do Departamento de Fisiologia e Patologia Bruno Galvão, Gisely Abílio, José Nascimento, Vinícius Perez e Wallace Blohem. Também colaboraram as estudantes de Biomedicina Giselly Araújo e Paloma Cândido.
De acordo com o estudo, as amostras foram coletadas em embalagens fechadas, individuais e não violadas de 1 kg, no período de fevereiro a julho de 2020. Segundo o coordenador da pesquisa, Wallace Felipe Blohem, em todas elas foi possível observar o crescimento microbiano, tanto de bactérias quanto de fungos.

Ao todo, das 10 amostras, apenas duas – do bairro Bancários – apresentaram contagens de bactérias e fungos dentro dos limites aceitáveis para o consumo humano, que consiste em 500.000 bactérias e 1.000 fungos, conforme a Comissão Nacional de Normas e Padrões para Alimentos.
“A contagem elevada desses micro-organismos na goma de mandioca pode indicar condições higiênicas inadequadas nos processos de produção, manipulação e embalagem do produto. Portanto, não é dentro do supermercado que acontece essa contaminação, mas, sim, no processo primário de obtenção da goma”, relatou o Prof. Wallace.
Os resultados apontam para necessidade de melhorias no método de preparação e preservação do produto. Além disso, mostra a necessidade de reforçar as fiscalizações quanto às boas práticas de fabricação e manipulação, a fim de garantir a segurança alimentar dos consumidores.
A falta dessas condições higiênicas pode ocasionar infecções alimentares, que são a principal consequência da ingestão desses micro-organismos. Infecções alimentares estão associadas com distúrbios gastrointestinais, como vômito e diarreia.
O pesquisador contou que escolheu a goma de mandioca por ser um alimento de grande importância e por se tratar de um dos principais produtos cultivados no Brasil. “Dados acerca do consumo da fécula ou goma de mandioca na região Nordeste do Brasil apresentam um aumento significativo no estado da Paraíba, por isso o interesse em desenvolver uma pesquisa nessa temática”, explicou o Prof. Wallace.
O docente ainda relatou que existem outros resultados da pesquisa, entretanto, ainda não podem ser divulgados. Até o fim deste ano (2021), eles devem ser publicados em forma de artigo, na revista Scientia Plena, da Associação Sergipana de Ciência.
Em breve, os pesquisadores pretendem avaliar a goma de tapioca vendida em feiras livres de João Pessoa.
UFPB